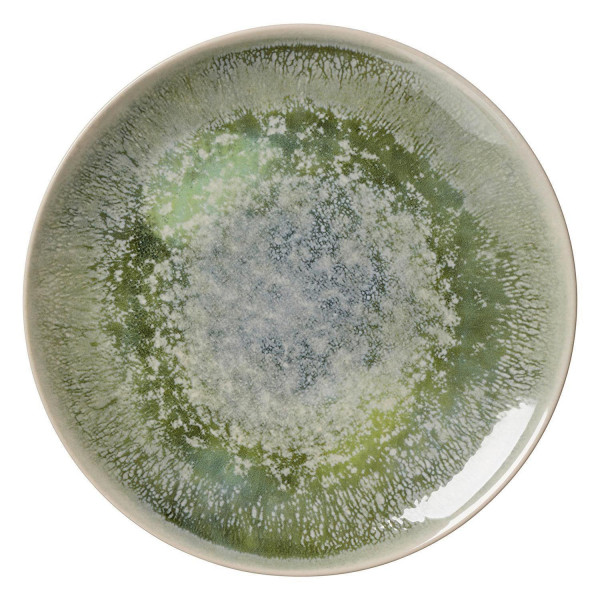

Der Artikel wurde erfolgreich hinzugefügt.
Ritzenhoff & Breker
Speiseteller CECINA
Ø 26 cm - Grün - Beige - Steinzeug - mit schimmernder Farbschattierung
Art.-Nr. 000599015410000
- Speiseteller in Grün
- mit einem Durchmesser von 26 cm
- aus Steinzeug
- spülmaschinenfest
- schimmernde Farbschattierung in Beige
Artikelverfügbarkeit:
Abholung in
Aschaffenburg / Sulzbach
Aschaffenburg / Sulzbach
Sofort abholbereit
Verfügbar
Abholung in
Bad König
Bad König
Sofort abholbereit
Verfügbar
Lieferung
Lieferzeit 1 - 3 Tage
Verfügbar
Die Lieferzeit ist abhängig vom verfügbaren Lagerbestand.
Ausgestellt in Aschaffenburg 3.OG und Bad König EG
Produktdetails
| Marke: | Ritzenhoff & Breker |
| Lieferumfang: | 1 Speiseteller |
| Farbe: | Beige, Grün |
| Muster: | Gemustert |
| Durchmesser: | 26 cm |
| Höhe: | 2,5 cm |
| Material: | Steinzeug |
| Anzahl: | 1 |
| Eigenschaften: | Made in Germany, Spülmaschinenfest |
| Versand: | Paket Standard |
Zusätzliche Informationen:
Der Speiseteller CECINA von Ritzenhoff & Breker vereint Funktionalität und stilvolles Design. In der Farbe Grün gehalten, besticht er durch seine schimmernde Farbschattierung in Beige. Mit einem Durchmesser von 26 cm und einer Höhe von 2,5 cm bietet er ausreichend Platz für vielfältige Gerichte. Hergestellt aus robustem Steinzeug ist der Teller spülmaschinenfest und damit perfekt für den täglichen Gebrauch geeignet.
Mehr lesen
Weniger lesen
}
Abholung / Lieferung
Click & Collect:
Dieser Artikel wird als Paket geliefert:
- Sie haben die Möglichkeit diesen Artikel kostenlos vor Ort in unseren Filialen Aschaffenburg oder Bad König abzuholen. Weitere Informationen zu unserem Click & Collect Service finden Sie hier.
Dieser Artikel wird als Paket geliefert:
- Ihre Bestellung wird als Paket an Ihre Wunschadresse geliefert. Falls Sie tagsüber nicht zuhause sind, können Sie Ihr Produkt auch an Familie, Freunde oder ins Büro liefern lassen. Dafür geben Sie einfach eine separate Lieferadresse zur Rechnungsadresse an. So sind Sie total flexibel!
- Sollte die Zustellung einmal nicht möglich sein, nimmt der Paketdienstleister Ihr Produkt zur erneuten Anlieferung wieder mit oder gibt das Paket beim Nachbarn ab. Eine entsprechende Benachrichtigungskarte finden Sie dann in Ihrem Briefkasten.
- Die Lieferkosten als Paket können Sie am einfachsten im oberen Bereich der Artikelseite unter dem Verkaufspreis des Artikels mit Klicken des Wortes „Lieferkosten“ einsehen.
- Lieferumfang: Ohne Dekoration
Mehr lesen
Weniger lesen
Hersteller & Sicherheit
Herstellerangaben
Jetzt ansehenWarn- und Sicherheitshinweise
Jetzt ansehen

Kundenbewertungen